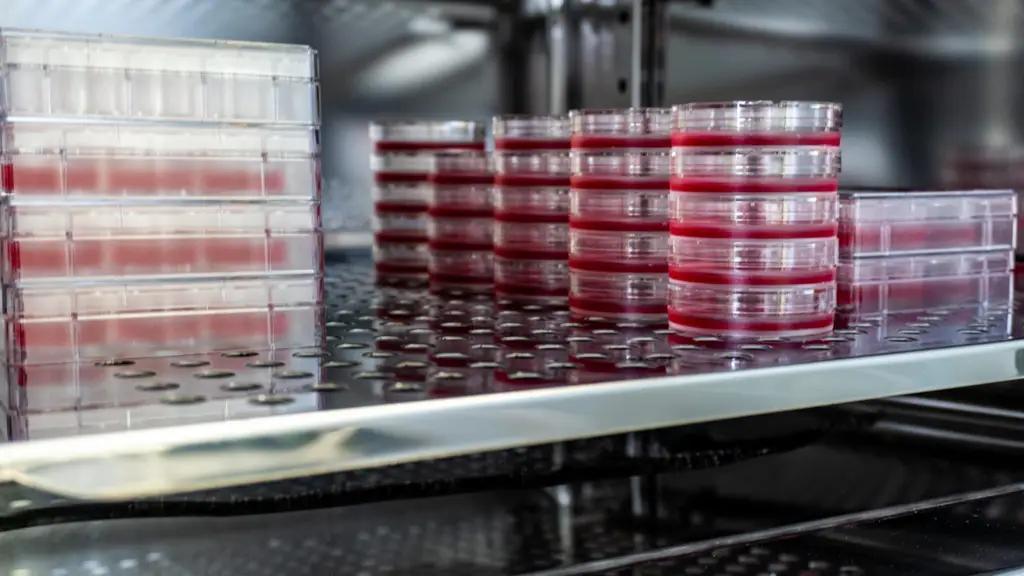
Для ветеринарной службы закупили холодильное оборудование для хранения биоматериалов

Опубликовано
12.12.2025, 13:42Служба ветеринарии, развития животноводства, пастбищ и кормов закупила специальное холодильное оборудование для всех районных и городских управлений с целью обеспечения надлежащих условий хранения ветеринарных биопрепаратов, финансируемых за счет республиканского бюджета.
В настоящее время активно ведутся работы по доставке и установке оборудования в регионах. Эта мера создает условия для безопасного, качественного и соответствующего стандартам хранения ветеринарных биопрепаратов и вносит значительный вклад в повышение эффективности работы ветеринарной службы.
Благодаря использованию нового холодильного оборудования работы по профилактике заболеваний животных, а также по сохранению качества лекарственных средств и вакцин будут проводиться еще более эффективно. Это, в свою очередь, способствует защите и развитию животноводства в стране.
Будьте в курсе! Подписывайтесь на наш Telegram.



